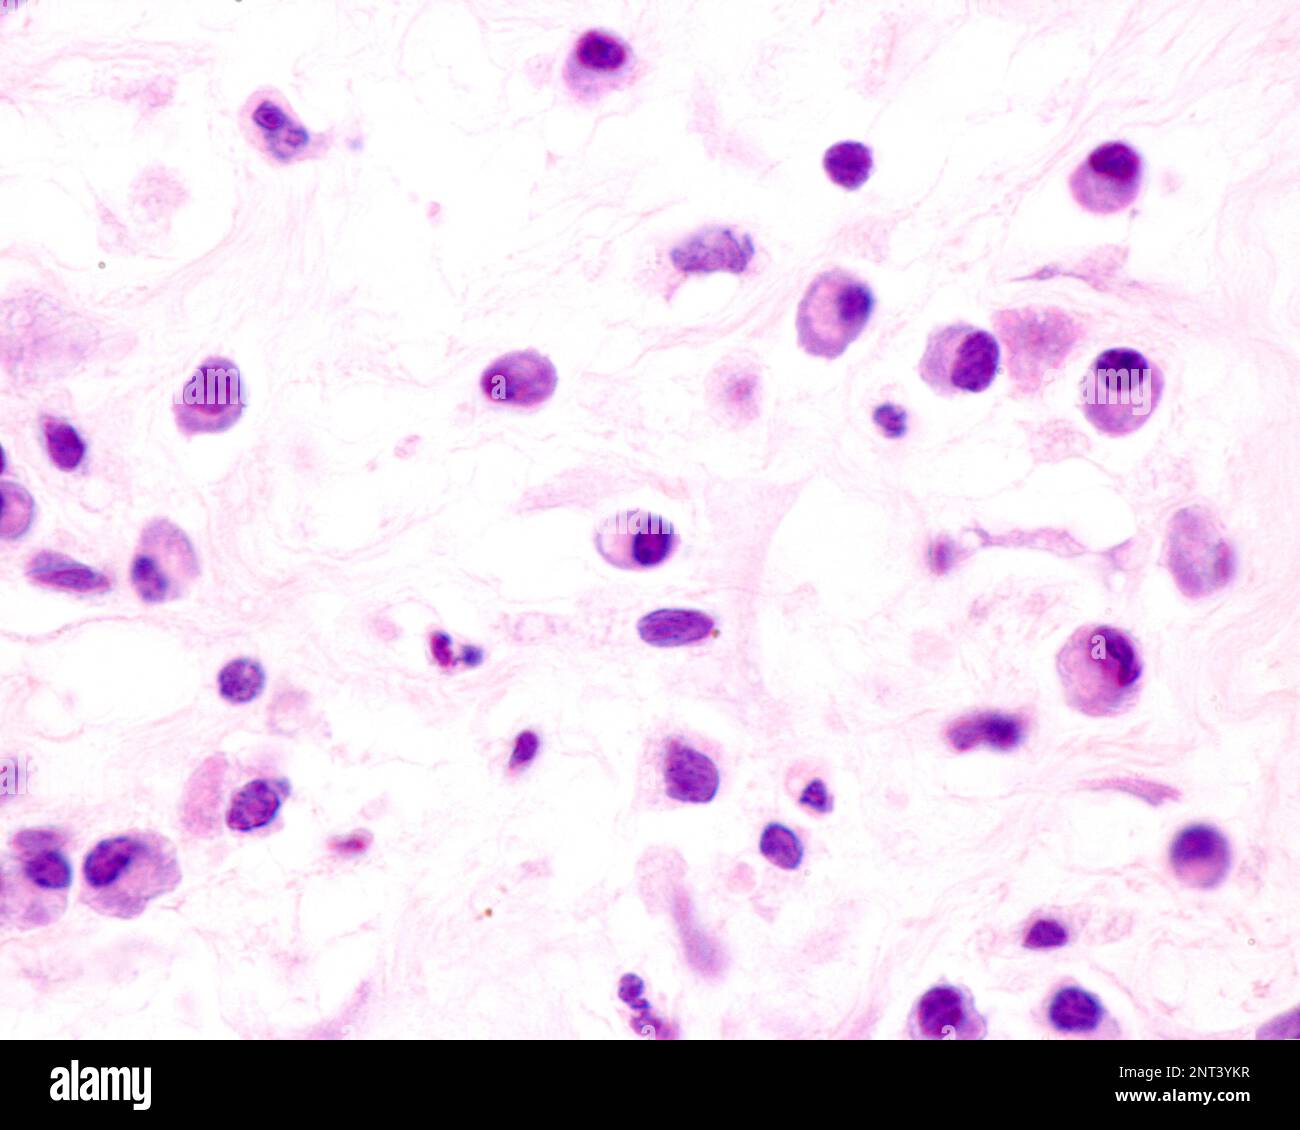
Le cellule plasmatiche sono linfociti B attivati dalla presenza di antigeni che secernono grandi quantità di anticorpi. Compaiono nei tessuti affetti da c Foto Stock

Le cellule plasmatiche sono linfociti B attivati dalla presenza di antigeni che secernono grandi quantità di anticorpi. Compaiono nei tessuti affetti da c
RFID:ID dell’immagine:2NT3YKR
Detagli dell'immagine
Collaboratore:
Jose CalvoID dell’immagine:
2NT3YKRDimensioni dei file:
33,8 MB (702,2 KB Download compresso)Liberatorie:
Modello - no | Proprietà - noMi occorre una liberatoria?Dimensioni:
3840 x 3072 px | 32,5 x 26 cm | 12,8 x 10,2 inches | 300dpiData acquisizione:
8 febbraio 2023Altre informazioni: